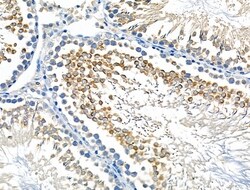

Promotional price valid on web orders only. Your contract pricing may differ. Interested in signing up for a dedicated account number?
Learn More
Learn More
Invitrogen™ STK36 Polyclonal Antibody


Rabbit Polyclonal Antibody
Supplier: Invitrogen™ PA5106734
Description
Antibody detects endogenous levels of total STK36.
Serine/threonine protein kinase required for postnatal development, possibly by regulating the homeostasis of cerebral spinal fluid or ciliary function. Controls the activity of the transcriptional regulators GLI1, GLI2 and GLI3 by opposing the effect of SUFU and promoting their nuclear localization. GLI2 requires an additional function of STK36 to become transcriptionally active, but the enzyme does not need to possess an active kinase catalytic site for this to occur.
Specifications
| STK36 | |
| Polyclonal | |
| Unconjugated | |
| STK36 | |
| 1700112N14Rik; B930045J24; FU; Fused; Fused homolog; Kiaa1278; mKIAA1278; serine/threonine kinase 36; serine/threonine kinase 36 (fused homolog, Drosophila); serine/threonine-protein kinase 36; STK36; testicular tissue protein Li 188 | |
| Rabbit | |
| Affinity Chromatography | |
| RUO | |
| 269209, 27148, 301516 | |
| -20°C | |
| Liquid |
| Immunohistochemistry (Paraffin), Western Blot, Immunocytochemistry | |
| 1 mg/mL | |
| PBS with 50% glycerol and 0.02% sodium azide; pH 7.4 | |
| Q69ZM6, Q9NRP7 | |
| STK36 | |
| A synthesized peptide derived from human STK36(Accession Q9NRP7), corresponding to amino acid residues D386-A436. | |
| 100 μL | |
| Primary | |
| Human, Mouse, Rat | |
| Antibody | |
| IgG |
Safety and Handling
WARNING: Cancer - www.P65Warnings.ca.gov
Product Content Correction
Your input is important to us. Please complete this form to provide feedback related to the content on this product.
Product Title
Spot an opportunity for improvement?Share a Content Correction